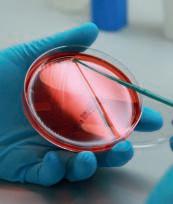

De associatie
gebruik en resistentie in de rundveesector
In verdiepend onderzoek, onderdeel binnen de Data-analyse, is onderzocht of op sectorniveau, voor de groep van melkveebedrijven en niet-melkleverende rundveebedrijven, associaties konden worden aangetoond tussen het gebruik van groepen van antibiotica enerzijds en resistentievorming in specifieke bacteriesoorten tegen deze antibioticumgroepen anderzijds. In de afgelopen jaren zijn opvallende trends waargenomen in de monitoring van de antibioticumresistentie (AMR) van ziekteverwekkende bacteriën. Of deze trends samenhangen met trends in het antibioticumgebruik (AMU) is echter onbekend. Door AMU-gegevens te koppelen aan gegevens over AMR op basis van gevoeligheidsbepalingen die bij GD zijn uitgevoerd, was het mogelijk te analyseren of een toe- of afnemende mate van resistentie tegen antibiotica geassocieerd is met veranderingen in het gebruik. Dit is gedaan door de hoeveel heid geleverde antibiotica per antibioticumgroep, op sectorniveau per kwartaal (melkleverende bedrijven) of per jaar (niet-melkleverende bedrijven) te vergelijken met het percentage resistente isolaten per kwartaal of per jaar. Voor melkleverende bedrijven waren van 22 bacterie -




tussen antibioticum
soorten AMR-gegevens beschikbaar vanaf 2016 tot en met 2019. Om een analyse uit te kunnen voeren dienden voldoende gegevens beschikbaar te zijn: tenminste twintig isolaten per kwartaal in tenminste drie van de vier geanalyseerde jaren. Van zeven verschillende bacterie soorten en daarmee 53 kiem-antibiotica combinaties waren voldoende AMR-gegevens beschikbaar en werd per werkzame stof de associatie tussen AMU en AMR onderzocht. In totaal werd negen keer een trend of significante associatie gevonden tussen AMU en AMR, waarbij het acht keer een associatie met AMR van bacteriën uit melk van runderen met (sub)klinische mastitis betrof. Voor nietmelkleverende bedrijven zijn AMR-gegevens opgenomen van de negen meest frequent geïsoleerde bacteriesoorten, bij drie bacteriesoorten werd een associatie gevonden tussen AMU en AMR.
In deze verdieping werd voor een aantal combinaties van antibioticumgroepen en bacteriën een positieve associatie gevonden: hoger gebruik betekent hogere mate van resistentie en een lager gebruik een lagere resistentie in hetzelfde kwartaal. In principe zouden de resultaten van dit soort analyses bruikbaar kunnen zijn bij het opstellen van formularia en daarmee kunnen bijdragen aan verantwoord AMU en het reduceren van AMR in veterinaire pathogenen in de rundveesector. Echter, om resultaten uit een dergelijke analyse te gebruiken is het wenselijk om te beschikken over meer gegevens. In deze analyse is gebruik gemaakt van resultaten van isolaten uit nietaangestuurde monsters, wat de resultaten niet geheel representatief maakt voor de Nederlandse rundveepopulatie. Meer gericht monsters/isolaten uit het veld halen zou de representativiteit van de AMR verbeteren. Hierdoor kunnen de resultaten van een dergelijke analyse nog meer van waarde zijn en een verantwoord antibioticumgebruik verder ondersteunen.

Via het Veekijkernieuws houden wij u elk kwartaal op de hoogte van nieuws uit de monitoring van diergezondheid bij rundvee. Mocht er tussendoor iets belangrijks spelen dan sturen wij u daarover een bericht.

Aanmelden
sectiemateriaal
U kunt dieren bij GD 24 uur per dag, 7 dagen per week aanmelden voor pathologisch onderzoek. Dit kan via www.gddiergezondheid.nl/ ophaaldienst of via 0900-2020012. Wij halen dieren die ’s avonds voor 22.00 uur zijn aangemeld de eerstvolgende werkdag op. Belt u ’s ochtends voor 9.00 uur? Dan bekijkt de planner of de opdracht nog in de route past. Voor een optimaal onderzoek is het van belang een goede en volledige anamnese toe te voegen, vers materiaal in te sturen (koelen in warme tijden) en een dier te selecteren dat representant is van het probleem waar u een antwoord op wilt hebben.
Rundvee | Maart 2021

Geleverde sojaschroot met salmonella
Een voeradviseur belde de Veekijker over een melkveebedrijf waar vijf dagen lang een met Salmonella-gecontamineerde partij soja door het gemengd rantsoen was gevoerd (Total Mixed Ration). Een sojafabriek had deze partij, via een fouragehandelaar, aan verschillende veehouders geleverd. Nadat bekend werd dat de soja met salmonella was gecontamineerd, zijn de besmette partijen weer opgehaald. GD heeft in samenspraak met de voeradviseur deze casus gemeld bij de NVWA. Ook adviseerde GD om waakzaam te blijven op eventuele klinische symptomen, zoals koorts, diarree en verwerpen bij de dieren op het betreffende melkveebedrijf en de bedrijfsdierenarts te informeren. Een salmonella-uitbraak is uitgebleven.
Aanvoer (import)dieren: risico van
insleep van dierziektes waaronder paratbc
In 2020 werd GD geconsulteerd vanwege aanvoer van Jerseykoeien uit Denemarken, waarbij paratbc werd aangetoond in mestmonsters van een aantal dieren. Naast de directe schade, omdat de paratbc-positieve dieren moeten worden afgevoerd, kan ook op lange termijn schade optreden omdat de paratbc-besmetting pas later tot uiting kan komen en dan reeds is verspreid naar andere dieren op het bedrijf. Bekend is dat aangevoerde dieren een risicofactor zijn voor de insleep van dierziektes. Daarom wordt bij aanvoer van dieren van bedrijven met een lagere- of onbekende status een aanvoercontrole uitgevoerd. In een Deense studie (Jakobsen et al., Prev. Vet. Med. 2000, 15-27) is beschreven dat paratbc vaker wordt aangetoond bij:
• Jerseys;
• oudere koeien (pariteit hoger dan vier);
• eerste maand na afkalven;
• grotere bedrijven.
Multiresistente E. coli infectie bij opfokkalveren
De Veekijker ontving vragen over meerdere opfokkalveren (leeftijd 4 tot 10 weken) op een melkveebedrijf met koorts, luchtwegproblemen, neurologische verschijnselen en dikke gewrichten.
Op basis van de klinische verschijnselen is in overleg besloten twee kalveren in te sturen voor pathologisch onderzoek. Eén kalf had hersenvliesontsteking, sepsis en polyarthritis en de andere polyserositis en sepsis, beiden als gevolg van een multiresistente Escherichia coli. Salmonella- en mycoplasma-onderzoek was negatief.
Dit beeld is wel bekend bij vleeskalveren aan het einde van de mestperiode, maar niet bij
opfokkalveren. Een derdekeusantibioticum bleek nodig om de uitbraak te stoppen en daarna zijn er geen nieuwe gevallen meer bijgekomen.
Het advies was de stallen en de drinkautomaat zorgvuldig te reinigen en desinfecteren alvorens er nieuwe kalveren te huisvesten. Vanwege het ernstige ziekteverloop van de uitbraak is na overleg met bacteriologen van GD besloten miltmateriaal van de twee ingezonden kalveren te bewaren. Dit biedt de mogelijkheid om bij herhaling met behulp van typering de geïsoleerde stammen te kunnen vergelijken, waardoor meer inzicht kan worden verkregen in de epidemiologie op dit bedrijf.
Bel de Veekijker
Op werkdagen kunt u rechtstreeks contact opnemen met de Veekijker: 0900 - 710 00 00. Via het keuzemenu kiest u de diersoort waar u informatie over wilt hebben. Het team rund is bereikbaar van 08.30-12.00 uur en 12.45-17.00 uur.

Rundertuberculose in België
In december werd een geval van rundertuberculose gemeld in België, via een Promed- en een DGZ-nieuwsbericht. Het ging om een rund, geboren in 2017, verdacht van rundertuberculose tijdens de slacht. PCR-analyse en microscopisch onderzoek toonde geen mycobacterie aan, maar bij bacteriologisch onderzoek werd Mycobacterium bovis gekweekt. Het rund was afkomstig van een melkveebedrijf met 278 runderen uit de regio Luik. Het bedrijf is naar aanleiding van deze bevinding tot haard van tuberculose verklaard. Bij alle runderen van dit bedrijf en bij runderen op 59 contactbedrijven is vervolgens de tuberculinetest uitgevoerd. Het epidemiologisch onderzoek loopt nog. In België werd twee jaar geleden de laatste haard gemeld. België is op Europees niveau officieel vrij van rundertuberculose sinds 2003. Deze casus heeft geen impact op deze status volgens het Federaal Agenschap voor de Veiligheid van de Voedselketen (FAVV) in België.
V.l.n.r.: Jasper het Lam, Sanne Carp-van Dijken, Jan Muskens, Linda van Wuyckhuise, Paul Wever, Patty Penterman, Evert van Garderen, Inge Nijhoving en Debora Smits
Resistentie ontwikkeling bacteriën melkveebedrijven 2020 op een rij
GD rapporteert gedurende het jaar de resistentie-ontwikkeling van bacteriën uit dierlijk materiaal van melkleverende en nietmelkleverende bedrijven. Deze informatie komt van bacteriologisch onderzoek waarbij ziekteverwekkende bacteriën worden gekweekt. Een gevoeligheidsbepaling wordt daarbij uitgevoerd om na te gaan voor welke antibiotica deze bacterie onder laboratoriumomstandigheden gevoelig is. Aan de hand hiervan kan de dierenarts een onderbouwde keuze maken voor een bepaald antibioticum ter behandeling van de betreffende bacteriële infectie. Met de resultaten van alle uitgevoerde gevoeligheidsbepalingen kan over langere perioden de ontwikkeling van de gevoeligheidspatronen van bacteriën worden gevolgd. Wanneer de aantallen isolaten van een bepaalde ziekteverwekker in een kwartaal lager zijn dan twintig, dienen de resultaten met terughoudendheid te worden geïnterpreteerd. In dergelijke gevallen worden vergelijkingen niet op kwartaalniveau uitgevoerd maar één keer per jaar. Hier worden alleen significante (P-waarde van <0,05) en relevante veranderingen in antibioticumgevoeligheid besproken. Van multiresistente wordt gesproken als een bacterie voor tenminste drie verschillende antibioticumgroepen resistent is.
* De onderzochte isolaten zijn afkomstig van dode dieren (isolaten uit sectiemateriaal) of van zieke dieren (isolaten uit nietsectiemateriaal), waardoor de weergegeven resistentiepercentages niet noodzakelijk representatief zijn voor de hele Nederlandse rundveehouderij.
Pathogene bacteriën uit dierlijk materiaal van melkveebedrijven in 2020*
Het percentage multiresistente isolaten uit materiaal van runderen van melkveebedrijven is in 2020 gelijk aan het percentage in 2019, 2017 en 2016 maar significant lager dan in 2018: 43 procent in 2020 en 2019 (n=636 en n=584), 52 procent in 2018 (n=630) en 46 procent in zowel 2017 (n=706) als 2016 (n=670). Net als in de voorgaande vier jaren is van de volgende pathogenen meer dan 50 procent van de isolaten multiresistent: Escherichia coli F5 (=K99), E. coli, Salmonella Typhimurium en als Salmonella groep B getypeerde isolaten (zie figuur 1). De percentages multiresistentie voor de individuele pathogenen waren in 2020 niet significant verschillend van de percentages in 2019, met uitzondering van Salmonella Dublin waarvoor het percentage is gestegen van 0 procent in 2019 (n=60) naar 6 procent in 2020 (n=77). Het percentage is daarmee terug op het niveau van 2016 (n=92; 5 procent).
Pathogene bacteriën uit melkmonsters in 2020
Onder ziekteverwekkers uit melkmonsters is, na een significante daling (p<0,001) van het percentage multiresistente isolaten van in 2013 (9 procent), 2014 (7 procent) en 2015 (4 procent), het percentage in 2016 tot en met 2020 niet verder gedaald. Net als voorgaande vijf jaren is het percentage in 2020 (n=2.728) 4 procent. Het percentage multiresistente isolaten loopt voor de verschillende bacteriesoorten/-groepen uiteen van 0,1 tot 9 procent (zie figuur 2). Voor Klebsiella species, Streptococcus agalactiae en Streptococcus dysgalactiae werd helemaal geen multiresistentie aangetoond. Van Citrobacter species en Enterobacter cloacae zijn onvoldoende isolaten onderzocht. Het percentage multiresistente coagulase-negatieve stafylokokken daalde van 12 procent in 2019 (n=362) naar 7 procent in 2020 (n=247); in 2016 was dit percentage ook zo laag (6 procent; n=453), waarna het een aantal jaren hoger was (10 procent in 2017 (n=433) en 9 procent in 2018 (n=386)). De lagere percentages multiresistentie ten opzichte van isolaten uit ander materiaal dan melk, hangen onder andere samen met het testen van gevoeligheid voor minder antibioticumgroepen bij mastitisverwekkers. Isolaten uit monsters anders dan melk worden getest op negen tot elf verschillende antibioticumgroepen en mastitisverwekkers uit melk voor antibiotica uit vijf tot zes verschillende groepen.
tegen antibiotica uit acht verschillende antibioticumgroepen aangetoond) (bron: GD-LIMS)
Figuur 1. Per pathogeen, het percentage isolaten uit materiaal van dieren van melkveebedrijven dat resistent is tegen antibiotica behorend tot verschillende antibioticumgroepen, 2020 (0=geen resistentie aangetoond, 8=resistentie
Figuur 2. Per pathogeen, het percentage isolaten uit melkmonsters dat resistent is tegen antibiotica behorend tot verschillende antibioticumgroepen, 2020 (0=geen resistentie aangetoond, 6=resistentie tegen
0 10 20 30 40 50 60 70 80 90 100 Escherichia coli F5 (=K99) Salmonella groep B Salmonella Typhimurium Escherichia coliPasteurella multocida Salmonella spp.Mannheimia haemolytica Salmonella Dublin 0 1 2 3 4 5 6 7 8 Melkleverende bedrijven - Rund 2020 Percentage isolaten Aantal antibioticumgroepen resistent
antibiotica uit vijf verschillende antibioticumgroepen aangetoond) (bron: GD-LIMS)
0123456 0 10 20 30 40 50 60 70 80 90 100 Escherichia coliCoag.-neg. Stafylokok Staph. aureusStrept. uberis Strept. dysgalactiae Klebsiella speciesStrept. agalactiae Aantal antibioticumgroepen resistent Mastitis-Rund2020 Percentage isolaten
Blauwtong: situatie Nederland en buitenland
GD voerde voor het ministerie van LNV de blauwtongscreening van 2020 uit. Er werden geen dieren met afweerstoffen aangetoond. Nederland behoudt daarmee haar vrijstatus. In het buitenland werden meldingen van besmette runderen met blauwtong type-8 gedaan in Frankrijk, Duitsland, Zwitserland en Luxemburg. Luxemburg was vrij sinds 2012 en is als toezicht zone toegevoegd. Uit Oost-Europa kwamen meerdere meldingen van blauwtong type-4.

Stijging inwendige vervetting bij rundvee
Uit onderzoek bleek dat in de periode 2018 tot maart 2019 een duidelijke stijging optrad van het percentage koeien met inwendige vervetting ten opzichte van de jaren 2007 tot 2017. Een ongewenste situatie. Bij koeien die in een te vette conditie afkalven, treedt doorgaans een sterkere daling van de voeropname op in de periode rondom het afkalven. Dergelijke koeien ondergaan een ernstigere en langdurige negatieve energiebalans in de transitieperiode en hebben een grotere kans op daarmee samenhangende aandoeningen zoals leververvetting, ketose en baarmoederontsteking. Het vetweefsel dat zich bij inwendige vervetting vormt speelt hierbij meer dan uitwendig vet (op het karkas) een belangrijke rol: het produceert signaalstoffen die zorgen dat de koe voor het afkalven al een ontstekingsrespons in het lichaam ontwikkelt. Om het aantal gezondheidsproblemen van koeien in de transitieperiode zoveel mogelijk te beperken, is het dan ook van groot belang om vervetting van koeien in de droogstand te voorkomen. Verder onderzoek naar de oorzaken van inwendige
vervetting bij melkkoeien is noodzakelijk, voordat kan worden vastgesteld of er maatregelen in de praktijk moeten worden genomen. In 2020 is het percentage dieren
ouder dan 1 jaar aangeboden ter sectie met inwendige vervetting, ondanks een lichte daling, nog altijd zeer hoog ten opzichte van de jaren voor 2017 (figuur 4).
Figuur 3. De toezichtzones per 14-01-2021 en verdeling per blauwtongserotype (bron: http: //ec.europa.eu/food/animals/docs/ad_control-measures_bt_restrictedzones-map.jpg)
% dieren met inwendige vervetting 2005 25 20 15 10 5 2010 2015 2020 Jaar
Figuur 4. Het jaarlijkse percentage ingezonden runderen ouder dan 1 jaar waarbij op sectie vervetting is vastgesteld
Diergezondheidsbarometer rundvee vierde kwartaal 2020
DIERZIEKTEN
SITUATIE NEDERLAND
Resultaat monitoring vierde kwartaal 2020
Artikel 15 GWWD meldings en bestrijdingsplichtige dierziekten (genoemd in artikel 2 van de ‘Regeling preventie, bestrijding en monitoring van besmettelijke dierziekten, zoönosen en TSE’s’)
Blauwtong (BT) Virusinfectie. Nederland officieel vrij sinds 2012 (alle serotypen). Jaarlijkse screening.
Brucellose (zoönose, infectie via diercontact of onvoldoende bereid voedsel)
BSE
Bacterie. Nederland officieel vrij sinds 1999. Bewaking via afweerstoffenonderzoek in bloedmonsters van verwerpers.
Prion-infectie. Nederland bij OIE-status ‘verwaarloosbaar risico’. Sinds 2010 bij bewaking geen gevallen meer vastgesteld (totaal tussen 1997–2009 88 gevallen).
Enzootische boviene leukose Virusinfectie. Nederland officieel vrij sinds 1999. Bewaking via onderzoek op afweerstoffen in tankmelk en bloedmonsters van slachtrunderen.
Nederland BTV-vrij, geen infecties vastgesteld.
BTV-8 meldingen Luxemburg, Duitsland, Zwitserland en Frankrijk.
Twaalf heronderzoeken, geen infecties aangetoond.
Geen infecties vastgesteld.
Geen infecties vastgesteld.
Lumpy Skin Disease (LSD) Virusinfectie. Nederland officieel vrij. Nooit infecties vastgesteld.
Miltvuur (zoönose, infectie via diercontact)
Bacterie. In Nederland niet aangetoond sinds 1994. Bewaking via bloed-uitstrijken van plotseling gestorven runderen.
Geen infecties vastgesteld.
Mond en klauwzeer (MKZ) Virusinfectie. Nederland officieel vrij sinds 2001. Geen infecties vastgesteld.
Rabiës (hondsdolheid) (zoönose, infectie via bijt- of krab wonden)
Rundertuberculose (TBC)
(zoönose, infectie via diercontact of onvoldoende bereid voedsel)
Virusinfectie. Nederland officieel vrij sinds 2012 (illegaal geïmporteerde hond).
Bacterie. Nederland officieel vrij sinds 1999. Bewaking via slachtrunderen.
Geen infecties vastgesteld.
Geen infecties vastgesteld. Meer besmettingen gemeld in België, Duitsland en Frankrijk.
Artikel 100 GWWD meldingsplichtige aandoeningen (ziekten die genoemd zijn in artikel 10 van de 'Regeling preventie, bestrijding en monitoring van besmettelijke dierziekten en zoönosen en TSE’s')
Campylobacter fetus ssp. venerealis en Tritrichomonas foetus
Leptospirose
(zoönose, infectie via diercontact of onvoldoende bereid voedsel)
Listeriose
(zoönose, infectie via onvoldoende bereid voedsel)
Salmonellose
(zoönose, infectie via diercontact of onvoldoende bereid voedsel)
Yersiniose (zoönose, infectie via diercontact of onvoldoende bereid voedsel)
Bacteriën. Nederland vrij sinds 2009. Bewaking van KI- en embryostations en bij dieren voor export.
Bacterie. Bestrijding op melkveebedrijven verplicht, op vleesveebedrijven vrijwillig.
Geen infecties vastgesteld.
Eén bedrijf met een tankmelkomslag; totaal zijn er in 2020 13 besmette bedrijven bevestigd.
Bacterie. Besmetting incidenteel bij rundvee aangetoond. Infectie aangetoond bij één verworpen vruchten en bij één ter sectie aangeboden rund.
Bacterie. Bestrijding op melkveebedrijven verplicht, op vleesveebedrijven vrijwillig.
Bacterie. Besmetting incidenteel aangetoond bij rundvee, met name bij verworpen vruchten.
Overige OIE lijst aangifteplichtige ziekten in Nederland
Boviene Virus Diarree (BVD)
Virusinfectie. Bestrijding op melkveebedrijven verplicht, op vleesveebedrijven vrijwillig.
94 procent van de melkveebedrijven heeft een gunstige tankmelkuitslag (landelijk programma).
Geen infectie vastgesteld bij sectie aangeboden rund. Geen Yersinia species gekweekt in melkmonsters.
84 procent van de melkveebedrijven heeft BVD-vrijstatus of BVDonverdachtstatus.
Bij niet-melkleverende bedrijven is dit 17 procent.
>>
Arnsbergstraat 7
Postbus 9, 7400 AA Deventer
DIERZIEKTEN
T. 0900 1770
info@gddiergezondheid.nl
www.gddiergezondheid.nl

Vervolg tabel
SITUATIE NEDERLAND
Overige OIE lijst aangifteplichtige ziekten in Nederland
Infectieuze Boviene Rhinotracheïtis (IBR)
Paratuberculose
Virusinfectie. Bestrijding op melkveebedrijven verplicht, op vleesveebedrijven vrijwillig.
Bacterie. In Nederland bestrijding op melkveebedrijven verplicht. 99 procent heeft een PPN-status.
Tekenziekten Parasiet die infecties kan overbrengen. Teken besmet met Babesia divergens, Anaplasma phagocytofilia en Mycoplasma wenyonii komen voor in Nederland.
Overige infectieuze aandoeningen bij rundvee
BCK
Leverbot
Neosporose
Q koorts (zoönose, infectie via stof of onvoldoende bereid voedsel)
Uit de Monitoring
Virusinfectie. In Nederland komen infecties met Ovine herpesvirus type 2 incidenteel voor.
Parasiet. Leverbot komt algemeen voor in Nederland vooral in waterrijke/natte gebieden.
Parasiet. In Nederland een belangrijke infectieuze oorzaak van verwerpen.
Bacterie. In Nederland bij rund andere stam dan bij geiten en relatie met ziektegevallen bij mens niet vastgesteld.
Resultaat monitoring vierde kwartaal 2020
77 procent van de melkveebedrijven heeft IBR-vrijstatus of IBRonverdachtstatus. Bij nietmelkleverende bedrijven is dit 20 procent.
78 procent van de melkveebedrijven heeft PPN-status A (‘onverdacht’).
Geen infecties vastgesteld.
Eén infecties vastgesteld bij sectie.
Op 34 bedrijven infecties vastgesteld.
Infectie aangetoond in vijf ingezonden verworpen vruchten.
Eén infectie vastgesteld bij ingezonden verworpen vruchten.
Lebmaagaandoeningen als hoofddiagnose bij pathologie van jonge fokkalveren neemt toe.
Aantal Udder Cleft Dermatitis (UCD) als pathologie hoofddiagnose blijft toenemen.
Schmallenberg aangetoond bij kalf met aangeboren afwijkingen. Data analyse Rundersterfte ouder dan 1 jaar blijft verhoogd.
De levensduur van de veestapel neemt toe.
Ondanks lichte stijging van het percentage gesloten bedrijven blijft aanvoer van dieren met een lagere dierziektestatus (inclusief import) een risico.
Uiergezondheid vermindert en antibioticumgebruik voor mastitis neemt toe.
Antibioticumgevoeligheid melkveebedrijven
Antibioticumgevoeligheid niet melkleverende bedrijven
Geen bijzonderheden.
Geen bijzonderheden.

Monitoring Diergezondheid
Sinds 2002 voert Royal GD de diergezondheidsmonitoring in Nederland uit in nauwe samenwerking met onder andere de diersectoren, het bedrijfsleven, het ministerie van LNV, dierenartsen en veehouders. De informatie die in de monitoring wordt gebruikt, wordt op verschillende manieren verzameld waarbij het initiatief gedeeltelijk bij dierenartsen en veehouders en gedeeltelijk bij Royal GD ligt. De informatie wordt integraal geïnterpreteerd om de doelstellingen van de monitoring, het snel signaleren van diergezondheidsproblemen enerzijds en het volgen van trends en ontwikkelingen anderzijds, te bereiken. Samen werken we aan diergezondheid in belang van dier, dierhouder en samenleving.
Royal GD
GD2348/03-21